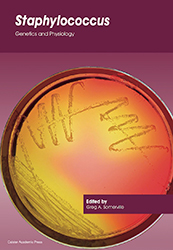
MT-Nov-17-reviews-staphylococcus.jpg

Reviews

Aquatic Biofilms: Ecology, Water Quality and Wastewater Treatment
Edited by A. M. Romaní, H. Guasch & M. D. Balaguer
Caister Academic Press (2016)
£159.00 ISBN 978-1910190173
Aquatic Biofilms is an excellent reference book for students, researchers or scientists who are working or interested in the topic. Various facets of biofilms in the aquatic environment are discussed, focusing on history, definition, type, structure, diversity, mechanisms, biogeochemistry, methodology and applications.
The book has been divided into three broad sections: ‘Biofilms Mode of Life’, ‘Biofilms and Pollution’ and ‘New Technologies using Biofilms’. The first section begins with what constitutes an aquatic biofilm, based on biotic and abiotic factors, followed by laser confocal microscopy techniques to study 3D architecture of biofilms. The role of cell–cell signalling – particularly quorum sensing in biofilm development and how such pathways can be used for development of novel targets – are discussed. An overview of microbial biodiversity in natural biofilms is presented next, and biogeochemical processes that occur in biofilms are explored. The second section concentrates on how biofilms can be used to monitor environmental pollution. Specifically, in what way the tolerance or sensitivity to diatoms present in biofilms is used to evaluate ecological aspects of aquatic sources is elucidated. Furthermore, the role of biofilms in detection of freshwater community ecotoxicology is also described. Reactions and physicochemical processes that occur in sewer biofilms are also covered in depth. The third and final section concludes with the newer role of biofilms in biodegradation of persistent organic pollutants and that of electroactive biofilms in removal of pollutants from water and air.
Aquatic Biofilms provides a unique perspective to biofilms in the aquatic environment with several illustrations and photographs to engage the readers. It offers a balanced view of aquatic biofilms, spanning from theory to application and from ecology to engineering, ensuring a holistic insight of environmental biofilms.
Arindam Mitra
Adamas University
The below reviews are published online in addition to those in the print or PDF copy of this issue of Microbiology Today.

Essential Human Virology
Written by J. Louten
Academic Press (2016)
£54.99 ISBN 978-0128009475
Described as for undergraduates, this book contains much more detail than is required to satisfy the learning outcomes of undergraduate microbiology-based modules, as it includes more information on the molecular and cellular aspects of viruses and the host response to infection. Therefore this book will be useful not just to undergrads but postgrads and probably postdocs as well. The book is divided into a total of 16 chapters, with the first eight presenting an introduction to virology; structure and classification; basic cellular and molecular biology; replication; transmission and epidemiology; the immune response; laboratory diagnosis; and the control, treatment and exploitation of viruses. The last eight chapters focus on specific viruses and types of infections, ending with a chapter on emerging and re-emerging infections. I was surprised however, not to find a mention of Zika virus. Chapters contain case studies as well as ‘in-depth look’ boxes, providing more focused studies of particular subject areas or issues. Each chapter ends with a summary of the key concepts, questions to help the reader assess their understanding, and examples of further reading. On the whole the Figures in the book are clear, although the text in a few of them is very small. The book claims an instructor website containing lectures, test questions and recommended activities but, unfortunately, I have not yet been able to access it. £54.99 is rather a lot for a student to afford, for a book focusing on virology but for the level of detail contained in it, I would say it was good value for money.
Christopher Ring
Middlesex University
Staphylococcus: Genetics and Physiology
Edited by G. A. Somerville
Caister Academic Press (2016)
£159 ISBN 918-1910190494
This book boasts an A-list of Staphylococcus experts together writing a 12-chapter tome. It kicks off with a history of S. aureus infections, perhaps unsurprisingly foreseeing a highly S. aureus slant to the book. The second chapter fills the reader in on the state of play in human infections whilst the third chapter leads us in to animal infections. It is perhaps a shame that we need to wait until Chapter 3 to find any figures or diagrams. However, here we are treated to a round-up, including several pictures of infections and a very interesting description of animal infection caused by Staphylococcus spp. Chapter 4 introduces us to several intriguing nuggets concerning Staphylococcus genomic variation and evolution, followed by Chapter 5 with a discussion of virulence factors. Metabolism comes in at Chapter 6, followed by proteomics at Chapter 7. Cell walls at Chapter 8 brings us a nicely laid out discussion and some very clear figures to illustrate a complicated scenario. Chapter 9 fills us in on transition metal homeostasis. By Chapter 10, discussion of all non-aureus staphylococci is complete and we finish off the book discussing stress responses, molecular strategies for antibiotic resistance, and Chapter 13’s immune responses to S. aureus. The latter chapter brings a new viewpoint on some complicated pathogenicity explaining immunological issues with mouse models, as well as reasons for the failure of several attempts at an S. aureus vaccine.
In short, if you are looking to equip yourself with a general understanding of staphylococci, particularly S. aureus, this could well be the book for you.
Lisa C. Crossman
SequenceAnalysis.co.uk and University of East Anglia
